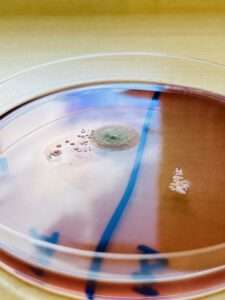
Hygiene

Herzlich Willkommen auf meiner Portfolioseite.



Das bin ich...
Als Leiter der Notfallsanitäterschule und stellv. Leitung der Desinfektorenschule bringe ich umfangreiche Führungskompetenzen in die Organisation und Leitung dieser Ausbildungsstätten ein. Meine Aufgaben umfassen die strategische Planung, die Entwicklung von Lehrplänen und die Sicherstellung einer hohen Ausbildungsqualität. Meine Ausbildung als Gesundheits- und Krankenpfleger, Notfallsanitäter und staatlich geprüfter Desinfektor bildet die Basis meiner umfassenden Fachkenntnisse und meiner Fähigkeit, sowohl theoretisches Wissen als auch praktische Fähigkeiten effektiv zu vermitteln.
Mein Name ist Daniel Piel, und ich freue mich, Ihnen einen Einblick in meine beruflichen Qualifikationen und Erfahrungen zu geben. Mit einem Bachelor-Abschluss in Medizinpädagogik und einem Master-Abschluss in Schulleitungsmanagement bringe ich eine fundierte akademische Basis und praxisorientierte Expertise in den Bereichen Gesundheitswesen und Notfallmedizin mit. Zudem bin ich staatlich geprüfter Desinfektor, Gesundheits- und Krankenpfleger sowie Notfallsanitäter.
Ich freue mich darauf, meine Expertise und Erfahrung in den Dienst Ihrer Gesundheit und Ausbildung zu stellen. Zögern Sie nicht, mich zu kontaktieren, wenn Sie Fragen haben oder weitere Informationen benötigen.



Bereiche

Notfallmedizin
Rettungsdienst

Intensivmedizin
Krankenhaus

Hygiene
Desinfektion

Bildung
Lehre